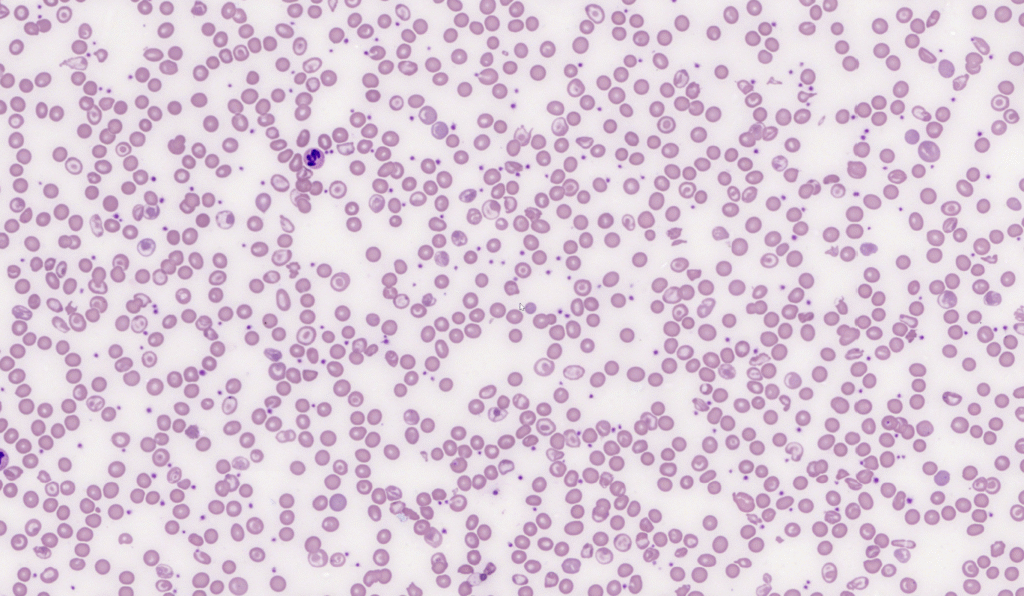
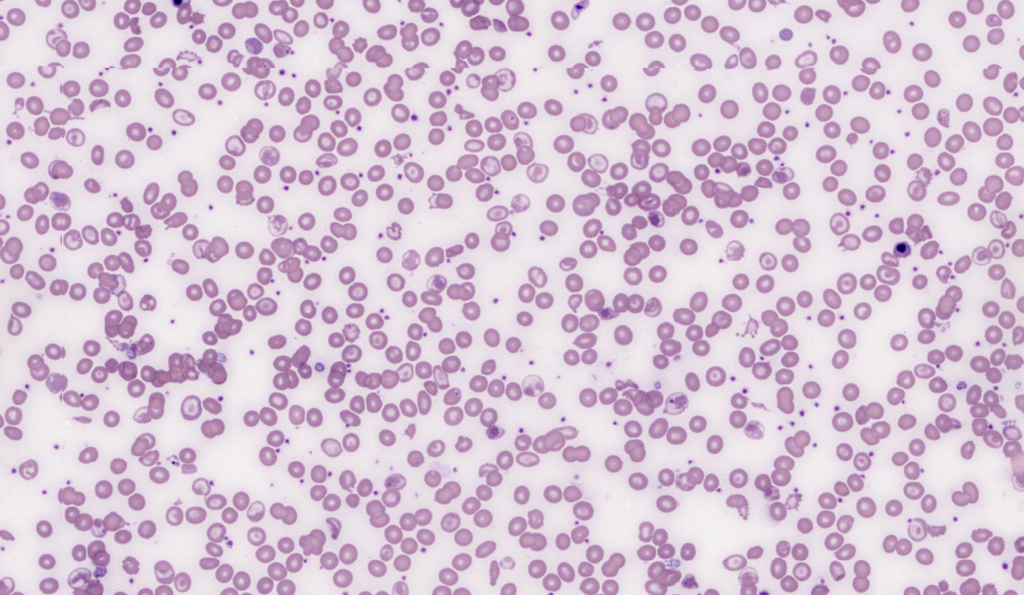
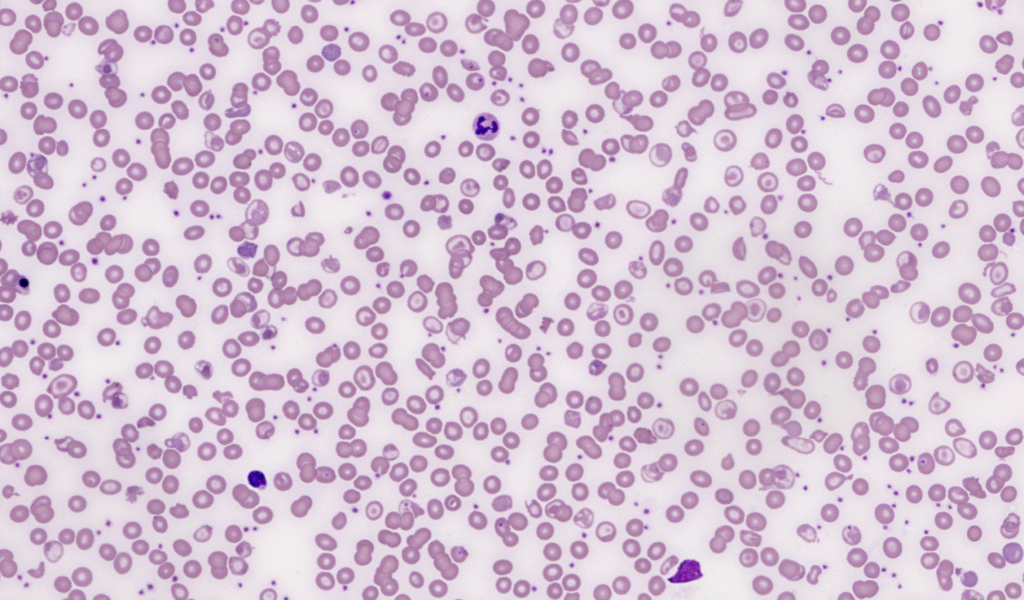

For today’s case, we are going to do something different. I will start by telling you the diagnosis:
The blood film images are from a transfusion dependent patient who is a compound heterozygote for HbE/beta-thalassaemia.

Beyond the underlying thalassaemia, the native red cell population shows very specific morphological features that hint at a surgical history.
- Given the morphological clues on the film, what organ is the patient missing?
- What specific features in the “native” cell population led you to this conclusion?
Feel free to leave your thoughts below, or join in the discussion on Linkedin and or X (Twitter).
______
Peripheral blood film images from LearnHaem.com.